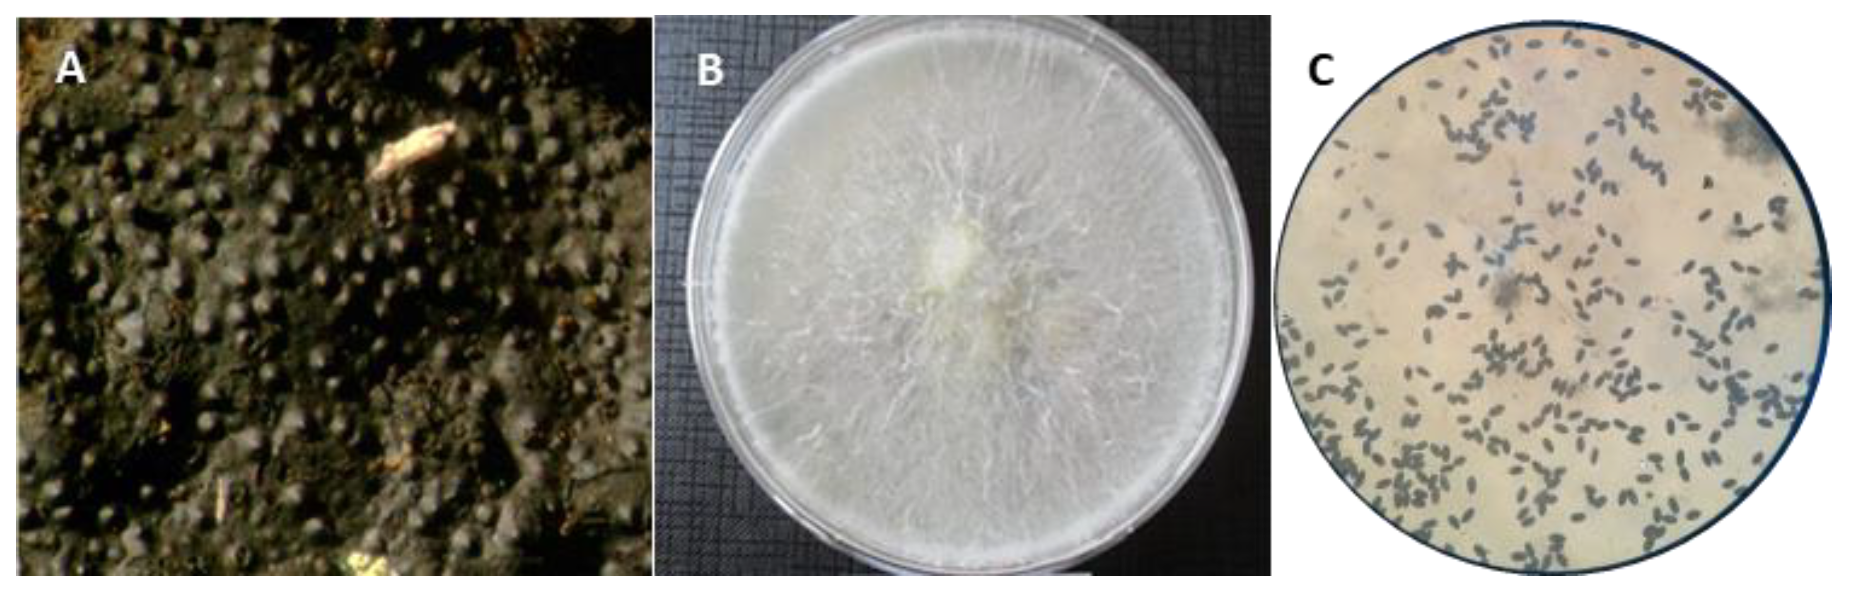
Forests 12 01032 g004 Forests 12 01032 g004

Status of Charcoal Canker on Oak Trees at a Site of Community Importance: Case Study of the Relict Castelfidardo Forest (SIC Area IT520008, Castelfidardo, AN, Italy)
Abstract
1. Introduction
2. Materials and Methods
2.1. Study Site, Plot Design, and Tree Health Assessment
2.2. Sample Collection, Mycological Analysis, and Morphological Identification
2.3. Molecular Identification of Fungal Colonies
2.4. Deadwood and Associated Lignicolous Macrofungi
2.5. Climatic Data
3. Results
3.1. Phytosanitary Monitoring
3.2. Mycological and Molecular Identification
3.3. Deadwood and Deadwood-Dwelling Mycobiota
3.4. Climatic Data
4. Discussion
5. Conclusions
Author Contributions
Funding
Data Availability Statement
Acknowledgments
Conflicts of Interest
References
- Manion, P.D. Tree Disease Concepts; Prentice-Hall N.J.: Englewood Cliffs, NJ, USA, 1991. [Google Scholar]
- Hennon, P.E.; D’Amore, D.; Wittwer, D.; Johnson, A.; Schaberg, P.; Hawley, G.; Beier, C.; Sink, S.; Juday, G. Climate warming, reduced snow, and freezing injury could explain the demise of yellow-cedar in southeast Alaska, USA. World Resour. Rev. 2006, 18, 427–450. [Google Scholar]
- Worrall, J.J.; Rehfeldt, G.E.; Hamann, A.; Hogg, E.H.; Marchetti, S.B.; Michaelian, M.; Gray, L.K. Recent declines of Populus tremuloides in North America linked to climate. For. Ecol. Manag. 2013, 299, 35–51. [Google Scholar] [CrossRef]
- Bendixsen, D.P.; Hallgren, S.W.; Frazier, A.E. Stress factors associated with forest decline in xeric oak forests of south-central United States. For. Ecol. Manag. 2015, 347, 40–48. [Google Scholar] [CrossRef]
- Gaylord, M.L.; Kolb, T.E.; McDowell, N.G. Mechanisms of piñon pine mortality after severe drought: A retrospective study of mature trees. Tree Physiol. 2015, 35, 806–816. [Google Scholar] [CrossRef] [PubMed]
- Ragazzi, A.; Vagniluca, S.; Moricca, S. European expansion of oak decline: Involved microorganisms and methodological approaches. Phytopathol. Mediterr. 1995, 34, 207–226. [Google Scholar]
- Henriques, J.; Inacho, M.L.; Lima, A.; Sousa, E. New outbreaks of charcoal canker on young cork oak trees in Portugal. IOBC-WPRS Bull. 2012, 76, 85–88. [Google Scholar]
- Conte, A.L.; Di Pietro, R.; Iamonico, D.; Di Marzio, P.; Cillis, G.; Lucia, D.; Fortini, P. Oak decline in the Mediterranean basin: A study case from the southern Apennines (Italy). Plant Sociol. 2019, 56, 69–80. [Google Scholar]
- Ciesla, W.M.; Donaubauer, E. Decline and Dieback of Trees and Forests: A Global Overview (No. 120); Food and Agriculture Org.: Rome, Italy, 1994. [Google Scholar]
- Führer, E. Oak decline in central Europe: A synopsis of hypotheses. In Proceedings: Population Dynamics, Impacts, and Integrated Management of Forest Defoliating Insects; General Technical Report NE-247; Kulhavy, D., Ross, W.G., Cahal, R.R., Eds.; USDA For. Serv: Radnor, PA, USA, 1998; pp. 7–24. [Google Scholar]
- Moricca, S.; Ragazzi, A. Fungal endophytes in Mediterranean oak forests: A lesson from Discula quercina. Phytopathology 2008, 98, 380–386. [Google Scholar] [CrossRef] [PubMed]
- Vannini, A.; Lucero, G.; Anselmi, N.; Vettraino, A. Response of endophytic Biscogniauxia mediterranea to variation in leaf water potential of Quercus cerris. For. Pathol. 2009, 39, 8–14. [Google Scholar] [CrossRef]
- Ghanbary, E.; Fathizadeh, O.; Pazhouhan, I.; Zarafshar, M.; Tabari, M.; Jafarnia, S.; Parad, G.A.; Bader, M.K.-F. Drought and pathogen effects on survival, leaf physiology, oxidative damage, and defense in two Middle Eastern oak species. Forests 2021, 12, 247. [Google Scholar] [CrossRef]
- Keča, N.; Koufakis, I.; Dietershagen, J.; Nowakowska, J.A.; Oszako, T. European oak decline phenomenon in relation to climatic changes. Folia For. Polon. Ser. A For. 2016, 58, 170–177. [Google Scholar] [CrossRef]
- Panzavolta, T.; Panichi, A.; Bracalini, M.; Croci, F.; Benigno, A.; Ragazzi, A.; Tiberi, R.; Moricca, S. Tree pathogens and their insect-mediated transport: Implications for oak tree die-off in a natural park area. Glob. Ecol. Conserv. 2018, 15, e00437. [Google Scholar] [CrossRef]
- Breshears, D.D.; Cobb, N.S.; Rich, P.M.; Price, K.P.; Allen, C.D.; Balice, R.G.; Romme, W.H.; Kastens, J.H.; Floyd, M.L.; Belnap, J.; et al. Regional vegetation die-off in response to global-change-type drought. Proc. Natl. Acad. Sci. USA 2005, 102, 15144–15148. [Google Scholar] [CrossRef]
- van Mantgem, P.J.; Stephenson, N.L.; Byrne, J.C.; Daniels, L.D.; Franklin, J.F.; Fulé, P.Z.; Harmon, M.E.; Larson, A.J.; Smith, J.M.; Taylor, A.H.; et al. Widespread increase of tree mortality rates in the western United States. Science 2009, 323, 521–524. [Google Scholar] [CrossRef] [PubMed]
- Allen, C.D.; Macalady, A.K.; Chenchouni, H.; Bachelet, D.; McDowell, N.; Vennetier, M.; Kitzberger, T.; Rigling, A.; Breshears, D.D.; Hogg, E.T.; et al. A global overview of drought and heat-induced tree mortality reveals emerging climate change risks for forests. For. Ecol. Manag. 2010, 259, 660–684. [Google Scholar] [CrossRef]
- Millar, C.I.; Stephenson, N.L. Temperate forest health in an era of emerging megadisturbance. Science 2015, 349, 823–826. [Google Scholar] [CrossRef] [PubMed]
- Mariotti, A.; Pan, Y.; Zeng, N.; Alessandri, A. Long-term climate change in the Mediterranean region in the midst of decadal variability. Clim. Dyn. 2015, 44, 1437–1456. [Google Scholar] [CrossRef]
- Polade, S.D.; Gershunov, A.; Cayan, D.R.; Dettinger, M.D.; Pierce, D.W. Precipitation in a warming world: Assessing projected hydro-climate changes in California and other Mediterranean climate regions. Sci. Rep. 2017, 7, 1–10. [Google Scholar] [CrossRef] [PubMed]
- Linaldeddu, B.T.; Sirca, C.; Spano, D.; Franceschini, A. Variation of endophytic cork oak-associated fungal communities in relation to plant health and water stress. For. Pathol. 2011, 41, 193–201. [Google Scholar] [CrossRef][Green Version]
- Moricca, S.; Linaldeddu, B.T.; Ginetti, B.; Scanu, B.; Franceschini, A.; Ragazzi, A. Endemic and emerging pathogens threatening cork oak trees: Management options for conserving a unique forest ecosystem. Plant Dis. 2016, 100, 2184–2193. [Google Scholar] [CrossRef]
- Brewer, S.; Cheddadi, R.; Beaulieu, J.L.; Reille, M. The migration of deciduous Quercus throughout Europe since the last glacial period. For. Ecol. Manag. 2002, 156, 27–48. [Google Scholar] [CrossRef]
- Bussotti, F.; Cenni, E.; Bettini, D.; Sarti, C.; Stergulc, F.; Feducci, M.; Capretti, P. Le condizioni dei boschi in Italia. Risultati dalle indagini estensive di Livello I (1997–2010). For. J. Silvic. For. Ecol. 2014, 11, 8–12. [Google Scholar]
- Taffetani, F. Boschi residui in Italia tra paesaggio rurale e conservazione. In Proceedings of the Atti del Terzo Congresso Nazionale di Selvicoltura per il Miglioramento e la Conservazione dei Boschi Italiani, Sicilia, Italy, 16–19 October 2008; Ciancio, O., Ed.; Accademia di Scienze Forestali: Florence, Italy, 2009. [Google Scholar]
- Aleffi, M.; Allegrini, M.C.; Fuffa, X.; Muccichini, S.; Tacchi, R. Briofite e Licheni delle Selva di Castelfidardo (Marche); Università degli Studi di Camerino: Camerino, Italy, 2005. [Google Scholar]
- Bernicchia, A.; Gorjòn, S.P. Polypores of the Mediterranean Region; Romar SRL: Verona, Italy, 2020. [Google Scholar]
- Consiglio, G.; Papetti, C. Funghi d’Italia Vol. 1-2-3 Ed; AMB: Trento, Italy, 2009. [Google Scholar]
- Volk, T.J.; Burdsall, H.H. A Nomenclatural Study of Armillaria and Armillariella Species (Basidiomycotina, Tricholomataceae); Fungiflora: Førde, Norway, 1995; p. 121. [Google Scholar]
- Doyle, J.J.; Doyle, J.L. Isolation of plant DNA from fresh tissue. Focus 1990, 12, 13–15. [Google Scholar]
- Mazzaglia, A.; Anselmi, N.; Vicario, S.; Vannini, A. Sequence analysis of the 5.8S rDNA and ITS regions in evaluating genetic relationship among some species of Hypoxylon and related genera. Mycol. Res. 2001, 105, 670–675. [Google Scholar] [CrossRef]
- White, T.; Bruns, T.; Lee, S.; Taylor, J. Amplification and direct sequencing of fungal ribosomal RNA genes for phylogenetics. In PCR Protocols: A Guide to Methods and Applications; Innis, M.A.G.D.H., Sninsky, J.J., White, T.J., Eds.; Academic Press, Inc.: New York, NY, USA, 1990; pp. 315–322. [Google Scholar]
- Mirabolfathy, M.; Groenewald, J.Z.; Crous, P.W. The occurrence of charcoal disease caused by Biscogniauxia mediterranea on chestnut-leaved oak (Quercus castaneifolia) in the Golestan Forests of Iran. Plant Dis. 2011, 95, 876. [Google Scholar] [CrossRef]
- Puigdefábregas, J.; Mendizabal, T. Perspectives on desertification: Western Mediterranean. J. Arid Environ. 1998, 39, 209–224. [Google Scholar] [CrossRef]
- Desprez-Loustau, M.-L.; Marcais, B.; Nageleisen, L.-M.; Piou, D.; Vannini, A. Interactive effects of drought and pathogens in forest trees. Ann. Forensic Sci. 2006, 63, 597–612. [Google Scholar] [CrossRef]
- Diffenbaugh, N.S.; Pal, J.S.; Giorgi, F.; Gao, X. Heat stress intensification in the Mediterranean climate change hotspot. Geophys. Res. Lett. 2007, 34, 1–6. [Google Scholar] [CrossRef]
- Leite, C.; Oliveira, V.; Miranda, I.; Pereira, E. Cork oak and climate change: Disentangling drought effects on cork chemical composition. Sci. Rep. 2020, 10, 1–8. [Google Scholar]
- Henriques, J.; Nóbrega, F.; Sousa, E.; Lima, A. Morphological and genetic diversity of Biscogniauxia mediterranea associated to Quercus suber in the Mediterranean Basin. Rev. Ciências Agrárias 2015, 38, 166–175. [Google Scholar]
- Linaldeddu, B.T.; Maddau, L.; Franceschini, A. First report of Diplodia corticola causing canker and dieback of Quercus ilex, Q. petraea, and Q. suber in Corsica (France). Plant Dis. 2017, 101, 256. [Google Scholar] [CrossRef]
- Anselmi, N.; Cellerino, G.P.; Franceschini, A.; Granata, G.; Luisi, N.; Marras, F.; Mazzaglia, A.; Mutto Accordi, S.; Ragazzi, A. Geographic distribution of fungal endophytes of Quercus sp. in Italy. In Endophytism in Forest Trees; Ragazzi, A., Moricca, S., Dellavalle, I., Eds.; Accademia Italiana di Scienze Forestali: Firenze, Italy, 2004; pp. 73–89. [Google Scholar]
- Vannini, A.; Valentini, R.; Luisi, N. Impact of drought and Hypoxylon mediterraneum on oak decline in the Mediterranean region. Ann. Sci. For. 1996, 53, 753–760. [Google Scholar] [CrossRef]
- Collado, J.; Platas, G.; Pelaez, F. Identification of an endophytic Nodulisporium sp. from Quercus ilex in central Spain as the anamorph of Biscogniauxia mediterranea by rDNA sequence analysis and effect of different ecological factors on distribution of the fungus. Mycologia 2001, 93, 875–886. [Google Scholar] [CrossRef]
- Moricca, S.; Capretti, P.; Dellavalle, I.; Ragazzi, A.; Turco, E. Differences in composition of endophytic mycobiota in twigs and leaves of healthy and declining Quercus species in Italy. For. Pathol. 2012, 33, 31–38. [Google Scholar]
- Sánchez-Salguero, R.; Colangelo, M.; Matías, L.; Ripullone, F.; Camarero, J.J. Shifts in growth responses to climate and exceeded drought-vulnerability thresholds characterize dieback in two Mediterranean deciduous oaks. Forests 2020, 11, 714. [Google Scholar] [CrossRef]
- Yangui, I.; Jamaâ, M.L.B.; Boutiti, M.Z.; Vettraino, A.M.; Vannini, A.; Messaoud, C. Occurrence of Biscogniauxia mediterranea in cork oak stands in Tunisia. Phytoparasitica 2021, 49, 131–141. [Google Scholar] [CrossRef]
- Jurc, D.; Ogris, N. First report outbreak of charcoal disease caused by Biscognauxia mediterranea on Turkey oak in Slovenia. Plant Pathol. 2006, 55, 299. [Google Scholar]
- Alidadi, A.; Kowsari, M.; Javan-Nikkhah, M.; Salehi Jouzani, G.R.; Ebrahimi Rastaghi, M. New pathogenic and endophytic fungal species associated with Persian oak in Iran. Eur. J. Plant Pathol. 2019, 155, 1017–1032. [Google Scholar] [CrossRef]
- Diminić, D.; Kranjec Orlović, J.; Lukić, I.; Ježić, M.; Ćurković Perica, M.; Pernek, M. First report of charcoaldisease of oak (Biscogniauxia mediterranea) on Quercus spp. in Croatia. Plant Dis. 2019, 103, 1–4. [Google Scholar] [CrossRef]
- Whalley, A.J.S. The xylariaceaous way of life. Mycol. Res. 1996, 100, 897–922. [Google Scholar] [CrossRef]
- Zambrano, J.; Cordeiro, N.J.; Garzon-Lopez, C.; Yeager, L.; Fortunel, C.; Ndangalasi, H.J.; Beckman, N.G. Investigating the direct and indirect effects of forest fragmentation on plant functional diversity. PLoS ONE 2020, 15, e0235210. [Google Scholar] [CrossRef] [PubMed]
- Lockwood, J.L.; Cassey, P.; Blackburn, T.M. The more you introduce the more you get: The role of colonization pressure and propagule pressure in invasion ecology. Divers. Distrib. 2009, 15, 904–910. [Google Scholar] [CrossRef]
- Panzavolta, T.; Panichi, A.; Bracalini, M.; Croci, F.; Ginetti, B.; Ragazzi, A.; Tiberi, R.; Moricca, S. Dispersal and propagule pressure of Botryosphaeriaceae species in a declining oak stand is affected by insect vectors. Forests 2017, 8, 228. [Google Scholar] [CrossRef]
- Greenwood, S.; Ruiz-Benito, P.; Martínez-Vilalta, J.; Lloret, F.; Kitzberger, T.; Allen, C.D.; Fensham, R.; Laughlin, D.C.; Kattge, J.; Bönisch, G.; et al. Tree mortality across biomes is promoted by drought intensity, lower wood density and higher specific leaf area. Ecol. Lett. 2017, 20, 539–553. [Google Scholar] [CrossRef] [PubMed]
- Martínez-Vilalta, J.; Lloret, F.; Breshears, D. Drought-induced forest decline: Causes, scope and implications. Biol. Lett. 2012, 8, 689–691. [Google Scholar] [CrossRef] [PubMed]
- Landmann, G.; Becker, M.; Delatour, C.; Dreyer, E.; Dupouey, J.L. Oak dieback in France: Historical and recent records, possible causes, current investigations. Zustand Gefährdung Laubwäder 1993, 5, 97–114. [Google Scholar]
- Oak, S.W.; Starkey, D.A.; Dabney, J.M. Oak decline alters habitat in southern upland forest. In Proceedings of the Annual Conference of the Southeast Association of the Fish and Wildlife Agencies, Hilton Head, SC, USA, 7–10 November 1988; Volume 42, pp. 491–501. [Google Scholar]
- Vannini, A.; Valentini, R. Influence of water relations in Quercus cerris-Hypoxylon mediterraneum interaction: A model of drought induced susceptibility to a weakness parasite. Tree Physiol. 1994, 14, 129–139. [Google Scholar] [CrossRef]
- Vannini, A.; Scarascia Mugnozza, G. Water stress: A predisposing factor in the pathogenesis of Hypoxylon mediterraneum on Quercus cerris. Eur. J. For. Path. 1991, 21, 193–202. [Google Scholar] [CrossRef]
- Nordén, B.; Ryberg, M.; Götmark, F.; Olausson, B. Relative importance of coarse and fine woody debris for the diversity of wood-inhabiting fungi in temperate broadleaf forests. Biol. Conserv. 2004, 117, 1–10. [Google Scholar] [CrossRef]
- Holub, S.M.; Spears, J.D.H.; Lajtha, K. A reanalysis of nutrient dynamics in coniferous coarse woody debris. Can. J. For. Res. 2001, 31, 1894–1902. [Google Scholar] [CrossRef]
- Laiho, R.; Prescott, C.E. The contribution of coarse woody debris to carbon, nitrogen, and phosphorus cycles in three Rocky Mountain coniferous forests. Can. J. For. Res. 1999, 29, 1592–1603. [Google Scholar] [CrossRef]
- Hagan, J.M.; Grove, S.L. Coarse woody debris. J. For. 1999, 97, 6–11. [Google Scholar]
- Allen, C.D.; Breshears, D.D.; McDowell, N.G. On underestimation of global vulnerability to tree mortality and forest die-off from hotter drought in the Anthropocene. Ecosphere 2015, 6, 129. [Google Scholar] [CrossRef]
- Holuša, J.; Lubojacký, J.; Čurn, V.; Tonka, T.; Lukášová, K.; Horák, J. Combined effects of drought stress and Armillaria infection on tree mortality in Norway spruce plantations. For. Ecol. Manag. 2018, 427, 434–445. [Google Scholar] [CrossRef]
- Shaw, C.G., III; Kile, G.A. (Eds.) Armillaria Root Disease; Agricultural Handbook No. 691; Forest Service, US Department of Agriculture: Washington, DC, USA, 1991.
- Heinzelmann, R.; Dutech, C.; Tsykun, T.; Labbé, F.; Soularue, J.P.; Prospero, S. Latest advances and future perspectives in Armillaria research. Can. J. Plant Path. 2019, 41, 1–23. [Google Scholar] [CrossRef]
- Moricca, S.; Bracalini, M.; Croci, F.; Corsinovi, S.; Tiberi, R.; Ragazzi, A.; Panzavolta, T. Biotic Factors Affecting Ecosystem Services in Urban and Peri-Urban Forests in Italy: The Role of Introduced and Impending Pathogens and Pests. Forests 2018, 9, 65. [Google Scholar] [CrossRef]
- Costa, D.; Tavares, R.M.; Baptista, P.; Lino-Neto, T. Cork Oak endophytic fungi as potential biocontrol agents against Biscogniauxia mediterranea and Diplodia corticola. J. Fungi 2020, 6, 287. [Google Scholar] [CrossRef] [PubMed]

| Plots | Area (m2) | Tree Species | Stand Density (Trees/100 m2) | Trees Monitored (n) |
|---|---|---|---|---|
| #1 | 6480.4 | Quercus pubescens + Fraxinus ornus | 11 | 51 |
| #2 | 8569.6 | Quercus pubescens + Fraxinus ornus | 9 | 49 |
| #3 | 6870 | Quercus robur + Carpinus betulus | 17 | 95 |
| #4 | 7700 | Quercus cerris + Carpinus orientalis | 15 | 162 |
| #5 | 8890 | Quercus cerris + Carpinus orientalis | 19 | 114 |
Publisher’s Note: MDPI stays neutral with regard to jurisdictional claims in published maps and institutional affiliations. |
© 2021 by the authors. Licensee MDPI, Basel, Switzerland. This article is an open access article distributed under the terms and conditions of the Creative Commons Attribution (CC BY) license (https://creativecommons.org/licenses/by/4.0/).
Share and Cite
Murolo, S.; Concas, J.; Salerno, A.; Maiorano, F.; Cingolani, L.; Carloni, F.; Moricca, S.; Romanazzi, G. Status of Charcoal Canker on Oak Trees at a Site of Community Importance: Case Study of the Relict Castelfidardo Forest (SIC Area IT520008, Castelfidardo, AN, Italy). Forests 2021, 12, 1032. https://doi.org/10.3390/f12081032
Murolo S, Concas J, Salerno A, Maiorano F, Cingolani L, Carloni F, Moricca S, Romanazzi G. Status of Charcoal Canker on Oak Trees at a Site of Community Importance: Case Study of the Relict Castelfidardo Forest (SIC Area IT520008, Castelfidardo, AN, Italy). Forests. 2021; 12(8):1032. https://doi.org/10.3390/f12081032
Chicago/Turabian StyleMurolo, Sergio, Jonathan Concas, Alessandro Salerno, Fedele Maiorano, Lorenzo Cingolani, Francesca Carloni, Salvatore Moricca, and Gianfranco Romanazzi. 2021. "Status of Charcoal Canker on Oak Trees at a Site of Community Importance: Case Study of the Relict Castelfidardo Forest (SIC Area IT520008, Castelfidardo, AN, Italy)" Forests 12, no. 8: 1032. https://doi.org/10.3390/f12081032
APA StyleMurolo, S., Concas, J., Salerno, A., Maiorano, F., Cingolani, L., Carloni, F., Moricca, S., & Romanazzi, G. (2021). Status of Charcoal Canker on Oak Trees at a Site of Community Importance: Case Study of the Relict Castelfidardo Forest (SIC Area IT520008, Castelfidardo, AN, Italy). Forests, 12(8), 1032. https://doi.org/10.3390/f12081032

